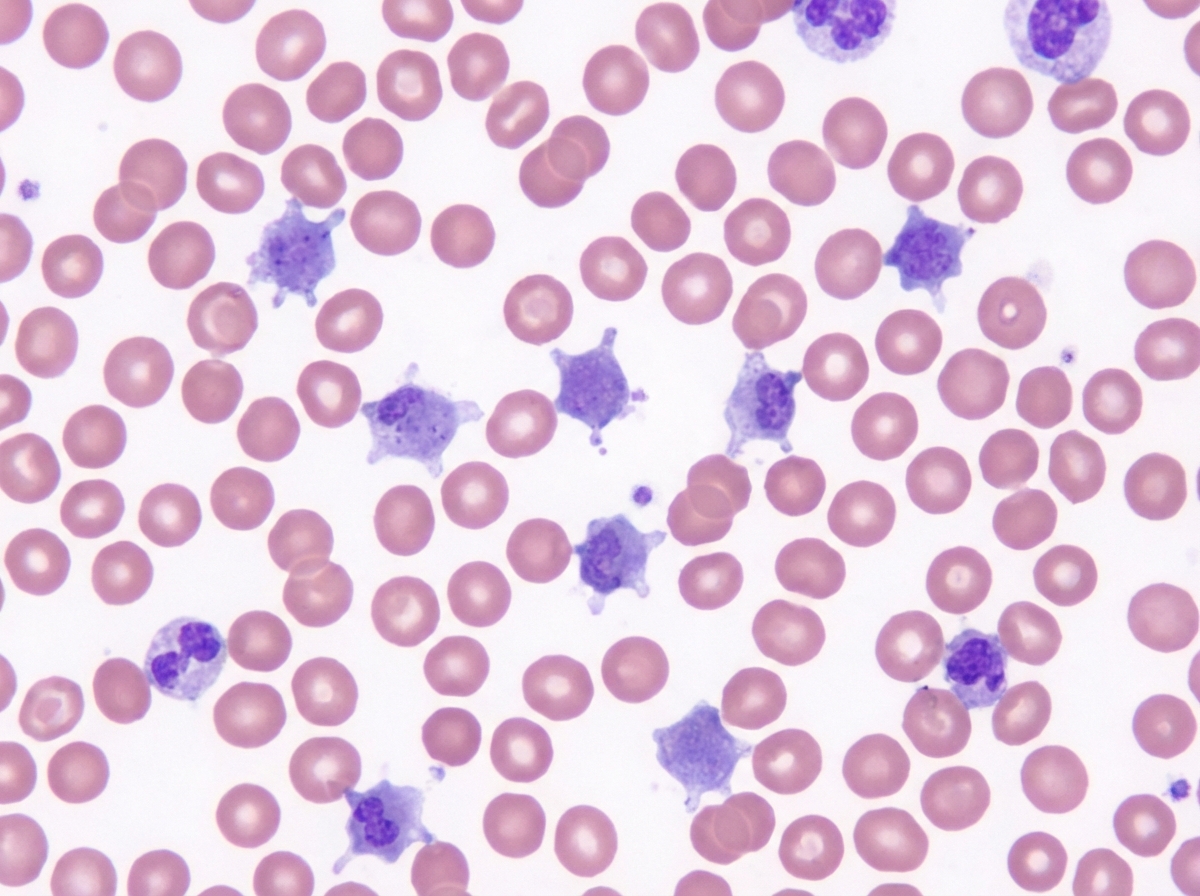
Image for question 331

Enter your email to get your 85% OFF code and unlock the full USMLE question bank on the app.
A 3-week-old boy is brought to the pediatrician by his parents for a circumcision. The circumcision was uncomplicated; however, after a few hours, the diaper contained blood, and the bleeding has not subsided. A complete blood count was ordered, which was significant for a platelet count of 70,000/mm3. On peripheral blood smear, the following was noted (figure A). The prothrombin time was 12 seconds, partial thromboplastin time was 32 seconds, and bleeding time was 13 minutes. On platelet aggregation studies, there was no response with ristocetin. This result was not corrected with the addition of normal plasma. There was a normal aggregation response with the addition of ADP. Which of the following is most likely true of this patient's underlying disease?
A 37-year-old man who had undergone liver transplantation 7 years ago, presents to the physician because of yellowish discoloration of the skin, sclera, and urine. He is on regular immunosuppressive therapy and is well-adherent to the treatment. He has no comorbidities and is not taking any other medication. He provides a history of similar episodes of yellowish skin discoloration 6–7 times since he underwent liver transplantation. Physical examination shows clinical jaundice. Laboratory studies show: While blood cell (WBC) count 4,400/mm3 Hemoglobin 11.1 g/dL Serum creatinine 0.9 mg/dL Serum bilirubin (total) 44 mg/dL Aspartate transaminase (AST) 1,111 U/L Alanine transaminase (ALT) 671 U/L Serum gamma-glutamyl transpeptidase 777 U/L Alkaline phosphatase 888 U/L Prothrombin time 17 seconds A Doppler ultrasound shows significantly reduced blood flow into the transplanted liver. A biopsy of the transplanted liver is likely to show which of the following histological features?
A 4-year-old male is evaluated for frequent epistaxis and mucous membrane bleeding. Physical examination shows diffuse petechiae on the patient’s distal extremities. Peripheral blood smear shows an absence of platelet clumping. An ELISA binding assay reveals that platelet surfaces are deficient in GIIb/IIIa receptors. Serum platelet count is normal. Which of the following is the most likely diagnosis?
An otherwise healthy 27-year-old man presents to the Emergency Department with dark urine and left flank pain. He has had a fever, sore throat, and malaise for the last 2 days. Vital signs reveal a temperature of 38.1°C (100.5°F), blood pressure of 120/82 mm Hg, and a pulse of 95/min. His family history is noncontributory. Physical examination reveals enlarged tonsils with tender anterior cervical lymphadenopathy. Urinalysis shows pink urine with 20–25 red cells/high power field and 2+ protein. This patient’s condition is most likely due to which of the following?
A 63-year-old man presents to the emergency department with periorbital swelling. He states that he was gardening, came inside, looked in the mirror, and then noticed his eyelids were swollen. He denies pain, pruritus, or visual disturbances. He states that he was drinking “a lot of water" to prevent dehydration, because it was hot outside this morning. His medical history is significant for rheumatoid arthritis. He takes methotrexate and acetaminophen as needed. The patient’s temperature is 98°F (36.7°C), blood pressure is 168/108 mmHg, and pulse is 75/min. Physical examination is notable for periorbital edema, hepatomegaly, and bilateral 1+ pitting lower extremity edema. Labs and a urinalysis are obtained, as shown below: Leukocyte count: 11,000/mm^3 Hemoglobin: 14 g/dL Serum: Na: 138 mEq/L K+: 4.3 mEq/L Cl-: 104 mEq/L HCO3-: 25 mEq/L Urea nitrogen: 26 mg/dL Creatinine: 1.4 mg/dL Glucose: 85 mg/dL Aspartate aminotransferase (AST, GOT): 15 U/L Alanine aminotransferase (ALT, GPT): 19 U/L Albumin: 2.0 g/dL Urine: Protein: 150 mg/dL Creatinine: 35 mg/dL An abdominal ultrasound reveals an enlarged liver with heterogeneous echogenicity and enlarged kidneys with increased echogenicity in the renal parenchyma. A biopsy of the kidney is obtained. Which of the following biopsy findings is associated with the patient’s most likely diagnosis?
A 24-year-old male was in a motor vehicle accident that caused him to fracture his femur and pelvis. After 2 days in the hospital, the patient became delirious, tachypneic, and a petechial rash was found in his upper extremities. Which of the following is most likely responsible for this patient’s symptoms?
A 19-year-old man comes to the physician for the evaluation of progressive difficulty climbing stairs over the last 2 years. During this period, he has also had problems with running, occasional falls, and standing from a chair. He has not had any vision problems or muscle cramping. There is no personal or family history of serious illness. Neurological examination shows deep tendon reflexes are 2+ bilaterally and sensation to pinprick and light touch is normal. Musculoskeletal examination shows enlarged calf muscles bilaterally. He has a waddling gait. Laboratory studies show a creatine kinase level of 1700 U/L. Which of the following is the most appropriate next step to confirm the diagnosis?
A 34-year-old man with AIDS comes to the physician because of a 2-day history of decreasing vision and seeing black spots in his right eye. He has no pain and the left eye is asymptomatic. He was treated for fungal esophagitis 6 months ago with fluconazole. He was diagnosed with Kaposi's sarcoma 2 years ago. Current medications include efavirenz, tenofovir, emtricitabine, azithromycin, trimethoprim-sulfamethoxazole, multivitamins, and a nutritional supplement. He is 170 cm (5 ft 7 in) tall and weighs 45 kg (99 lbs); BMI is 15.6 kg/m2. His temperature is 37°C (98.6°F), pulse is 89/min, and blood pressure is 110/70 mm Hg. Examination shows cervical lymphadenopathy. There are multiple violaceous plaques seen over his trunk and extremities. Fundoscopic examination shows granular yellow-white opacities around the retinal vessels and multiple areas of dot-blot hemorrhages. His CD4+ T-lymphocyte count is 36/mm3. Which of the following is the most likely diagnosis?
A 65-year-old man was picked up by the security personnel for voiding urine and defecating at an inappropriate place in the community. On questioning, he was making offensive remarks and behaving inappropriately. On physical examination, the physician observed signs of cognitive impairment and amnesia. Initial urine drug screen is negative for any drugs of abuse. Which is the most likely pathological finding present in this patient?
A 54-year-old woman comes to the physician because of a painful skin lesion on her right leg for 1 month. It initially started out as a small red spot but has rapidly increased in size during this period. She remembers an ant bite on her leg prior to the lesion occurring. She was treated for anterior uveitis 8 months ago with corticosteroids. She has Crohn's disease, type 2 diabetes mellitus, and hypertension. Current medications include insulin, mesalamine, enalapril, and aspirin. She returned from Wisconsin after visiting her son 2 months ago. Her temperature is 37.6°C (98°F), pulse is 98/min, and blood pressure is 126/88 mm Hg. Examination shows pitting pedal edema of the lower extremities. There is a 4-cm tender ulcerative lesion on the anterior right leg with a central necrotic base and purplish irregular borders. There are dilated tortuous veins in both lower legs. Femoral and pedal pulses are palpated bilaterally. Which of the following is the most likely diagnosis?
Liver pathology (hepatitis, cirrhosis)
Practice Questions
Gallbladder and biliary tract disorders
Practice Questions
Pancreatic diseases
Practice Questions
Kidney diseases
Practice Questions
Male reproductive pathology
Practice Questions
Female reproductive pathology
Practice Questions
Breast pathology
Practice Questions
Endocrine pathology
Practice Questions
Bone and joint pathology
Practice Questions
Skeletal muscle diseases
Practice Questions
Peripheral nerve disorders
Practice Questions
Soft tissue tumors
Practice Questions
Head and neck pathology
Practice Questions
Get full access to all questions, explanations, and performance tracking.
Scan to download app